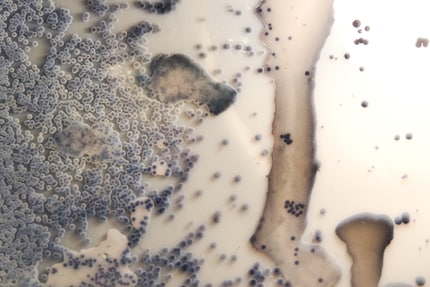

«Bacteria Lamp»
Would you get yourself a lamp like this?
- Definitely. Finally, a personalised, individual design.58%
- I'd rather not. I'll stick with conventional lamps.42%
The competition has ended.

Up-and-coming designer Jan Klinger from Stockholm shows just how personalised design can be with his lamp concept that integrates part of its owner. And by that I mean the person’s bacteria.
Some encounters really brighten your day. And that was certainly the case for me when I met Jan Klingler. I crossed paths with this industrial designer purely by chance when I was in Milan at one of the numerous «Salone del Mobile» events. Designers normally scurry around doing all their work behind the scenes and only emerge during the aperitifs. This time, Jan was making the most of his time to check out other projects, while I was using the opportunity to chat to him about his «infectious» lamps.
How did you come up with the «bacteria lamp» concept?
Jan Klingler: It grew out of my search for meaning and purpose in creative work. In this consumer-fuelled society we live in, I wanted to create strong and lasting relationships between my creations and their owners.
That’s why my first step was to take a hard look at my own possessions. They’ve moved with me five times within Europe over the last nine years, so they’ve gradually been whittled down. Alongside the essentials such as clothes, there were some unusual things that stuck out. For example, there was this bottle of aftershave that I can’t use because I got an allergic reaction. And yet it’s still one of my most prized possessions because it’s the only thing I have left of my grandfather who passed away. Whenever I see or smell the aftershave, I’m instantly reminded of happy moments with him.
That’s what encouraged me to create a similar, lasting and deep connection between my designs and their owners. In design terms, this translated into a container for memories and the most personal kind of content. And that’s how the light made of bacteria was born.
But why bacteria of all things?
Every living thing and every place has its own microbiological fingerprint. We can take samples of these, and they’re incredibly personal and unique. It could be from where you went on your first date or somewhere you have unforgettable holiday memories. It could even be the bacteria of someone you love who is far away. The options really are only limited by your imagination.
Why did you decide to design a light and not another kind of object?
On the whole, bacteria get quite a bad name in today’s society. By building bacteria into a light, I’m showing that these microbes aren’t just disease carriers but that they can also be seen as elegant objects with personal or sentimental value. The unique design and the upbeat colours help to make the bacteria captivating. People are then more receptive to learning more about the organisms and where they’ve come from.

How are the lamps made?
The lamp containers are hand-blown in glassworks in the south of Sweden called «The Glass Factory». Their shape draws on inspiration from laboratory glassware. But given the size of the containers, this work requires great skill. The rest of the stages in building the lamp are carried out in the laboratory to ensure what’s called biosafety in the workplace. This is where they conduct tests to make sure no microorganisms are used that are infectious for people. Finally, the containers are filled with a breeding ground for bacteria. After 24 to 48 hours in the incubator, the growth process is halted by a cast resin seal and the bacteria then become modern fossils.
How do you decide when a lamp has «finished growing»?
Unlike in controlled scientific experiments, the bacteria take on the role of an artist. The growth patterns surprise me every time. Even if you use the same bacteria, you’ll never get an identical pattern and this continues as it develops. But I still complete the growth process after at most 48 hours by covering the bacteria completely with resin.
Your designs show that two disciplines that didn’t have much of a connection can go hand in hand. Where does your interest in microbiology stem from?
I’ve always had diverse interests, which is why I found things difficult after sitting my school leaving exams. I was torn between medicine, biology and «something more creative» and I finally opted to study design. And I’ve never regretted it. A designer’s job is creative and incredibly interdisciplinary. By that I mean I can look at other subjects I’m interested in from a different angle and experiment and continue to learn from them.
How many people did you have to ask before you found a microbiologist to work on the project with you?
Surprisingly enough, not many. In Sweden, it’s easy to find interdisciplinary specialists. I was fortunate to meet Dr Volkan Özenci, a senior consultant and microbiologist. He took the time to explain the science side to me in Stockholm. And together we managed to develop a common language between the worlds of design and science.
I was the first industrial designer to be part of a development team. The things we designed included new laboratory glassware and tools that speed up and improve laboratory diagnosis of infectious diseases.
Why did you decide not to make a mass-market product?
The products that surround us are like an expression of ourselves. We keep growing and developing every day. That’s why it’s important to differentiate between the short-term and long-term emotional connection with people and products. Trends such as the fidget spinner are a great example of a short-term connection. As soon as every kiosk or street seller ended up with a large supply of them, the hype was already history. As an industrial designer, I want to create lasting connections between people and objects so that there’s a point and purpose to my designs.
What’s your favourite item at home right now?
A light that I got from a pillar in Östermalmstorg in Stockholm. That’s where I met my boyfriend for the first time. There’s a strong emotional connection to the piece as it always makes me think of the beginning of our relationship. I also have other items similar to the bacteria lamp, which I grew from microbes from friends and sights around the city. I think that people who have to move away for work, their studies or a relationship need to have a piece of their old home with them. That’s why I’m planning on creating an everlasting, abstract family portrait in the form of a bacteria lamp the next time I see my relatives and my partner’s family.
What projects are you going to work on next?
I’m currently working on more crossovers between microbiology and design. It won't be long until I get to unveil them and I can't wait.

Would you get yourself a lamp like this?
The competition has ended.
From the Slow Design series
Designers purposefully create things that don't need technology or slow down processes. It might seem strange, but these objects are meant to be sustainable and improve our well-being. My series shines a light on the home interior «slow design» trend by showcasing current examples.
Follow me by clicking on the «Follow author» button so you don’t miss a single interview. It'd be great if you could join me.
Like a cheerleader, I love celebrating good design and bringing you closer to everything furniture- and interior design- related. I regularly curate simple yet sophisticated interior ideas, report on trends and interview creative minds about their work.
Interesting facts about products, behind-the-scenes looks at manufacturers and deep-dives on interesting people.
Show all